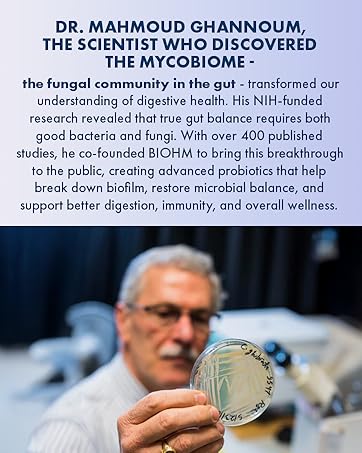

BIOHM Super Greens, Green Superfood Powder (8.5 Oz, 30 Servings) Antioxidant Veggie Powder & Smoothie Mix, 34 Superfoods & Spirulina, Digestive Enzymes, Prebiotics and Probiotics, Mixed Berry Flavor
$49.99
Price: $49.99
(as of Aug 29, 2025 22:14:46 UTC – Details)
From the brand

Shop our Probiotic Range








Shop our Superfood Powders






Package Dimensions : 4.49 x 3.66 x 3.58 inches; 8.47 ounces
Date First Available : June 23, 2021
Manufacturer : BIOHM Health
ASIN : B097S2RGMW
Best Sellers Rank: #93,252 in Health & Household (See Top 100 in Health & Household) #480 in Multi-Enzyme Nutritional Supplements
Customer Reviews: 4.3 4.3 out of 5 stars 282 ratings var dpAcrHasRegisteredArcLinkClickAction; P.when(‘A’, ‘ready’).execute(function(A) { if (dpAcrHasRegisteredArcLinkClickAction !== true) { dpAcrHasRegisteredArcLinkClickAction = true; A.declarative( ‘acrLink-click-metrics’, ‘click’, { “allowLinkDefault”: true }, function (event) { if (window.ue) { ue.count(“acrLinkClickCount”, (ue.count(“acrLinkClickCount”) || 0) + 1); } } ); } }); P.when(‘A’, ‘cf’).execute(function(A) { A.declarative(‘acrStarsLink-click-metrics’, ‘click’, { “allowLinkDefault” : true }, function(event){ if(window.ue) { ue.count(“acrStarsLinkWithPopoverClickCount”, (ue.count(“acrStarsLinkWithPopoverClickCount”) || 0) + 1); } }); });
GREENS POWDER WITH NATURAL INGREDIENTS – The BIOHM Super Greens powder supplement is naturally sourced with 34 superfoods, partnered with healthy probiotics, prebiotics and enzymes. Drink it with water or add it to your favorite beverage for a Super Greens powder boost!
HELPS SUPPORTS TOTAL GUT BALANCE- The gut is the epicenter of your overall health & wellness and contains both bacteria & fungi. Where ordinary probiotics only address bacteria, ignoring fungi’s critical role in digestion, we have designed a comprehensive approach of good bacteria + good fungi + digestive enzymes to help maintain a total gut balance
HELPS SUPPORT HEALTHY IMMUNE SYSTEM – The BIOHM daily Super Greens supplement with gut healthy ingredients is excellent for digestive health, immune support, and supports digestion for men and women. Simply add our Super Greens powder to your green juice or smoothie. A full-scale gut formula including lactobacillus acidophilus, lactobacillus rhamnosus, saccharomyces boulardii, and bifidobacterium probiotics
EASILY MIXES WITH NO CHUNKS – Ready to be mixed into your favorite beverage, BIOHM Super Greens is sure to leave behind no chunky residue. You would never believe it contains Organic Ashwagandha, Lions Mane Mushrooms, Reishi Mushroom, Raspberry, Ginger, Grape Seed Extract and many more high-antioxidant fruits. These assist in supporting cellular health, to help you feel your best each day
FRESH & NATURALLY SOURCED INGREDIENTS – Our Super Greens powder blend is packed with naturally sourced spirulina superfood powder, spinach leaf, broccoli crowns, wheat grass and barley grass, designed to support your body’s natural cleansing process*
SUGGESTED USAGE – Mix one scoop with 8 oz. of cold water, protein powder, yogurt or your preferred beverage. Try mixing with BIOHM Super Reds for an extra antioxidant boost. *These statements have not been evaluated by the Food and Drug Administration. This product does not intend to diagnose, treat, cure, or prevent any disease
User Reviews
Be the first to review “BIOHM Super Greens, Green Superfood Powder (8.5 Oz, 30 Servings) Antioxidant Veggie Powder & Smoothie Mix, 34 Superfoods & Spirulina, Digestive Enzymes, Prebiotics and Probiotics, Mixed Berry Flavor”
$49.99









There are no reviews yet.